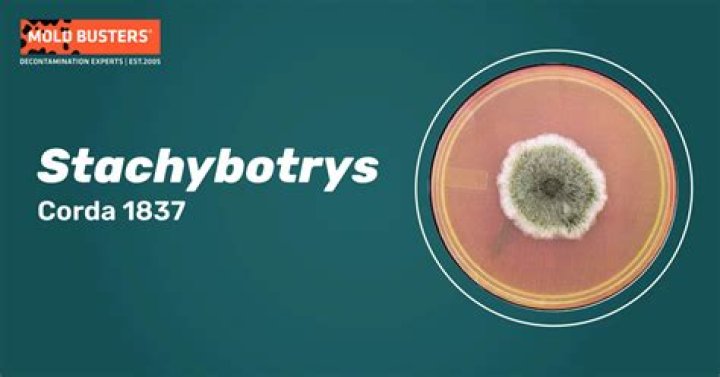

Is stachybotrys chartarum dangerous?
 John Hall
John Hall
This mold may cause human disease through direct irritation, type 1 hypersensitivity or the production of toxins. A variety of respiratory, dermatological, eye and constitutional symptoms have been associated with heavy and prolonged exposure to S chartarum.
How common is Stachybotrys chartarum?
In most studies, Stachybotrys has had a low prevalence, being present in less than 3% of samples (214, 267). However, some recent work has suggested that it may be more common than was initially thought (144, 405).
Can I stay in my house with black mold?
Can I Stay in My House With Black Mold? It is recommended that you stay somewhere clear of mold spores until all black mold has been removed from your home. This is because black mold is toxic and can cause immediate health issues and result in long-term consequences.
How do I know if my mold is Stachybotrys chartarum?
The best way to identify black mold (Stachybotrys chartarum) is by its color. Other mold species that grow in the house may be pink, gray, white or brown, but Stachybotrys -- true to its name -- is distinctively black.
Are all Stachybotrys toxic?
Stachybotrys, a common type of mold thought to be the most toxic, is actually a greenish-black in color but can be white or a slight pink color depending on the environment it is growing in and the food it “eats.” Mold of any color can be “toxic” under the right conditions, so using color as a red flag is a bad idea.
9 Signs You Have Toxic Mold In Your Home
17 related questions foundHow do I get rid of Stachybotrys?
Mold on hard surfaces can be cleaned with “commercial products, soap and water, or a bleach solution of no more than 1 cup of bleach in 1 gallon of water,” per the CDC's recommendation. Any time mold is being cleaned, non-porous gloves and eye wear should be worn, along with a mask.
How do you treat Stachybotrys?
Options include:- avoiding the allergen whenever possible.
- a nasal rinse, to flush mold spores out of the nose.
- antihistamines, to stop a runny nose, sneezing, and itchiness.
- decongestant nasal sprays, a short term remedy for congestion.
- nasal corticosteroids, to reduce inflammation.
- oral decongestants, to reduce congestion.
What does Stachybotrys smell like?
A musty, earthy smell, like dirt and rotting leaves, is a telltale sign of mold's presence. Stachybotrys smells especially strong. ... The smell almost guarantees mold. But even if you see mold, that's no guarantee that it's black mold.
What is an acceptable level of Stachybotrys?
Currently, there are no accepted guidelines when it comes to acceptable levels of fungal spores, including Stachybotrys spores. Many authors have proposed guidelines but they vary wildly and are largely unsubstantiated [1]. In our experience, anything above 50 spores per cubic metre should be cause for concern.
What should you do if you find black mold?
Create a bleach mixture
If the black mold growth in your home is small enough for you to treat alone, a simple mixture of bleach and water can help. Add one cup of bleach to one gallon of water and apply it to the moldy spots. You can also find commercial black mold removal products.
Is black mold an emergency?
Reasons Black Mold Is Hazardous
People who are around mold may start sneezing and coughing a lot. Their eyes may feel odd. They may start seeing strange rashes pop up on top of their skin. ... If you think that anyone in your home is affected by mold, then you have to seek emergency assistance from a doctor.
Is mold cancerous?
There's no evidence that mold causes cancer. If you're allergic to mold, your symptoms may be more severe, such as lung irritation.
Should I move if I have black mold?
Not only does mold damage the surfaces it grows on, it can also cause serious health problems. Depending on your sensitivity to mold and the extent of the mold growth, it could be a good idea to move out of your apartment if mold is present.
Is Stachybotrys fatal?
It sometimes produces toxic chemicals that are found in its airborne spores and fungus fragments. These are called mycotoxins and are dangerous if they're eaten. There's no link to inhaled Stachybotrys chartarum mycotoxins and deadly diseases.
Is Stachybotrys chartarum airborne?
chartarum trichothecene mycotoxins can become airborne in association with intact conidia or smaller particles. These findings may have important implications for indoor air quality assessment.
Is Stachybotrys airborne?
While growing, Stachybotrys colonies are moist (slime mold) and the spores are not easily aerosolized, but the spores can easily become airborne during demolition or when dry.
What kills Stachybotrys chartarum?
Using vinegar and borax, mix a cup of borax in a gallon of water, and then add a cup of vinegar. This solution kills mold on contact, whether you spray it or use it as a scrubbing solution. Tea tree oil or even vodka are also effective ingredients to try when killing mold.
What is a high Stachybotrys count?
100 cfu or less per cubic meter of air indicates low risk. 100 cfu to 1000 cfu per cubic meter of air indicates intermediate risk. 1000 or more cfu per cubic meter of air indicates a high risk. Many people believe that a count of 48 Stachybotrys or Chaetomium spores/m3 of air would be unusually high.
Is all black mold Stachybotrys?
Black toxic mold is also known as Stachybotrys chartarum and is dark black or sometimes dark green. It is a highly toxic form of mold commonly found in attics. This mold releases mycotoxins which are toxic chemicals that are present in mold spores that get released into the air and can then be inhaled.
What are the symptoms of Stachybotrys?
Commonly reported respiratory tract symptoms include nasal irritation, burning and congestion, cough, wheezing, chest tightness and dyspnea. Central nervous system manifestations include headache, irritability, lightheadedness, sleeping difficulty, concentration problems and mental fatigue.
Does black mole smell?
It's often described as musty and earthy, and may even smell like rotting vegetables or plants. You might notice a musty smell, but not be able to see any mold growing. ... An outsider should be able to smell the mold if you can't because your nose has adjusted to it.
How long does it take mold to make you sick?
These spores proliferate quickly and can take hold in places with poor ventilation and high humidity in less than 24 hours. The problem starts when you inhale these spores. They produce toxic substances known as mycotoxins that can produce an immune response in some individuals and actually extremely toxic themselves.
Where is Stachybotrys found?
It can be found in wet basements, attics and crawl spaces. Drywall or sheetrock is a great food source for mold. Stachybotrys loves materials high in cellulose and low in nitrogen.
Can mold grow in your lungs?
The mold spores can colonize (grow) inside lung cavities that developed as a result of chronic diseases, such tuberculosis, emphysema, or advanced sarcoidosis. The fibers of fungus might form a lump by combining with white blood cells and blood clots.
What are the dangers of black mold?
The most common black mold symptoms and health effects are associated with a respiratory response. Chronic coughing and sneezing, irritation to the eyes, mucus membranes of the nose and throat, rashes, chronic fatigue and persistent headaches can all be symptomatic of black mold exposure or black mold poisoning.



